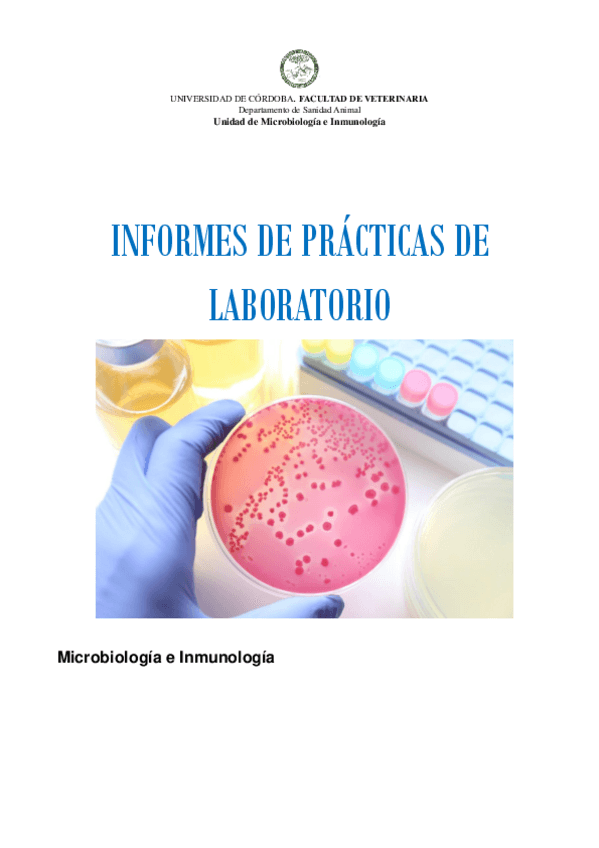

@user_2425406
19 Publicaciones
410 Interacciones
1 Seguidores
1 Siguiendo
Lista de publicaciones de user_2425406
He publicado nuevos apuntes de 2º Microbiología e Inmunología: Informes-de-practicas-de-laboratorio-20232024.pdf
apuntes
-
Prácticas 2023
He publicado nuevos apuntes de 2º Mejora Genética para la Cría y Salud Animal: Prácticas 2023
He publicado nuevos apuntes de 5º Aplicación de Metodologías Bioquímicas en Veterinaria: Block-III-y-IV-Nota-10.pdf
He publicado nuevos apuntes de 5º Aplicación de Metodologías Bioquímicas en Veterinaria: Block-I-Nota-10.pdf
apuntes
-
Temas 23-26
He publicado nuevos apuntes de 2º Mejora Genética para la Cría y Salud Animal: Temas 23-26
He publicado nuevos apuntes de 1º Análisis de Datos y Gestión Veterinaria: Excell-completo-Gestion.xlsx
He publicado nuevos apuntes de 1º Análisis de Datos y Gestión Veterinaria: Trabajo-de-campo-Nota-sobresaliente.pdf
He publicado nuevos apuntes de 2º Mejora Genética para la Cría y Salud Animal: Tema-22.pdf
He publicado nuevos apuntes de 2º Mejora Genética para la Cría y Salud Animal: Tema-21.pdf
He publicado nuevos apuntes de 1º Manejo de los Animales de interés veterinario: Memoria-de-practicas-20222023.pdf
He publicado nuevos apuntes de 2º Mejora Genética para la Cría y Salud Animal: Tema-20.pdf
He publicado nuevos apuntes de 1º Manejo de los Animales de interés veterinario: Caso-practico-Bruce.pdf
He publicado nuevos apuntes de 2º Mejora Genética para la Cría y Salud Animal: TEMA-19.pdf